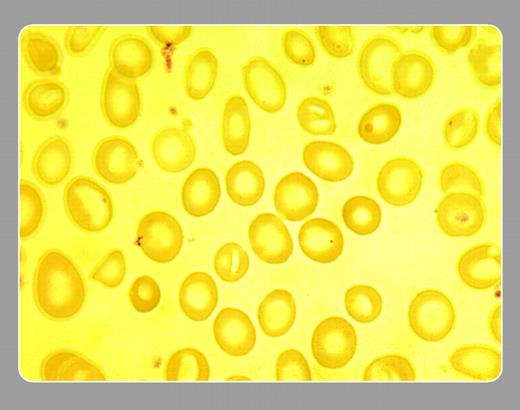
• Stanley Schrier, Stanford University School of Medicine

Topics:
iron deficiency
This is a flagrant example of severe iron deficiency anemia. Note the hypochromia with extreme central pallor and the microcytosis. In patients with more moderate degrees of anemia, the findings are more subtle but still point to the correct diagnosis.FIG1
The above image was first published in the ASH IMAGE BANK, a reference and teaching tool that is continually updated with new atlas images and images of case studies. For more information or to contribute to the Image Bank, visit www.ashimagebank.org.
Copyright © 2004 by The American Society of Hematology
2004